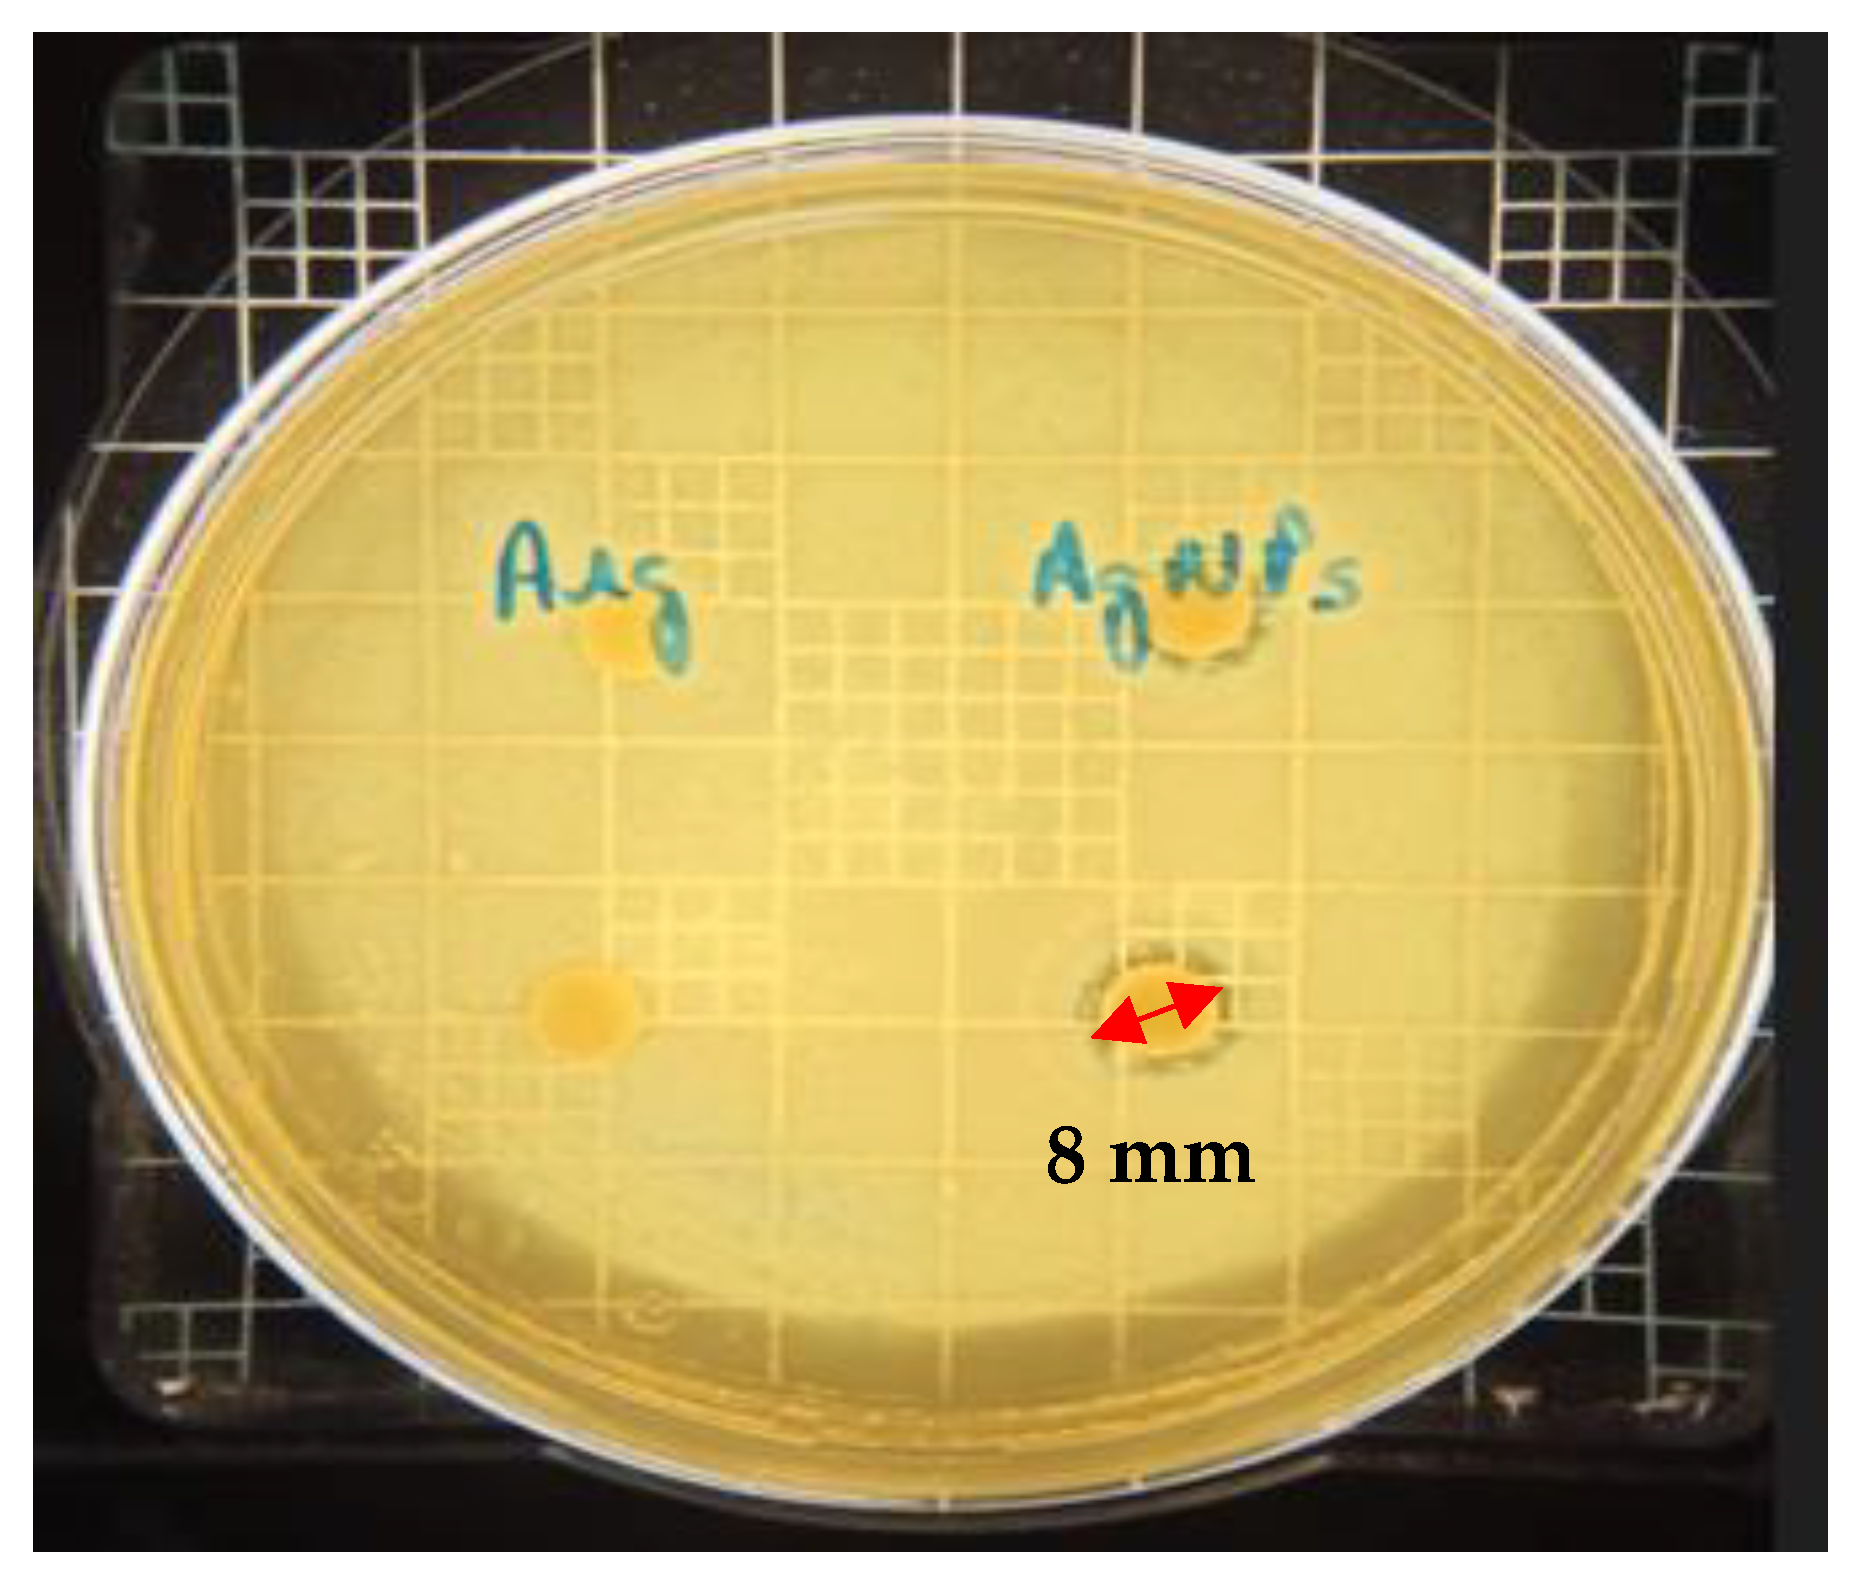
Antibiotics 12 00873 g006 Antibiotics 12 00873 g006

Cellulose Hydrogel with Hyaluronic Acid and Silver Nanoparticles: Sustained-Release Formulation with Antibacterial Properties against Pseudomonas aeruginosa
Abstract
1. Introduction
2. Results
2.1. Final Formulation of the Cellulose Hydrogel
2.2. Characterization of the Composite Consisting of Cellulose and Hyaluronic Acid (HA)
2.2.1. Scanning Electron Microscopy (SEM)
2.2.2. Characterization by FT-IR
2.2.3. Characterization by Differential Scanning Calorimetry (DSC)
2.3. Synthesis and Characterization of AgNPs
2.4. Antibacterial Activity Assays
2.4.1. Disk Diffusion on Agar Test
2.4.2. Determination of Minimum Inhibitory Concentration (MIC)
2.4.3. Time–Kill Assay
2.4.4. Data Analysis Statistical between Minimum Inhibitory Concentration (MIC) and Time–Kill
2.5. Cytotoxicity Assay with Human Red Blood Cells (RBC)
3. Discussion
4. Materials and Methods
4.1. Bacterial Strains
4.2. Synthesis of Silver Nanoparticles (AgNPs)
4.3. Characterization of Silver Nanoparticles (AgNPs)
4.3.1. UV-Vis Spectrophotometry
4.3.2. Particle Size Distribution
4.3.3. Cytotoxicity Assay with Human Red Blood Cells
4.4. Antibacterial Activity Assays for AgNPs
4.4.1. Disk Diffusion on Agar Test
4.4.2. Determination of Minimum Inhibitory Concentration (MIC)
4.4.3. Time–Kill Assay
4.4.4. Data Analysis Statistical
4.5. Cellulose Hydrogel Preparation
4.6. Hyaluronic Acid Hydrogel Preparation
4.7. Hydrogel Preparation of AH-Nanocellulose and AgNPs
4.8. Characterization of the Composite Consisting of Cellulose and Hyaluronic Acid
4.8.1. Scanning Electron Microscopy (SEM)
4.8.2. Fourier Transform Infrared Spectroscopy (FT-IR)
4.8.3. Differential Scanning Calorimetry (DSC)
5. Conclusions
6. Patents
Author Contributions
Funding
Institutional Review Board Statement
Informed Consent Statement
Data Availability Statement
Acknowledgments
Conflicts of Interest
References
- World Health Organization (WHO). Available online: http://who.int/news/item/27-02-2017-who-publishes-list-of-bacteria-for-which-new-antibiotics-are-urgently-needed (accessed on 26 February 2023).
- Sitarek, P.; Merecz-Sadowska, A.; Kowalczyk, T.; Wieczfinska, J.; Zajdel, R.; Śliwiński, T. Potential Synergistic Action of Bioactive Compounds from Plant Extracts against Skin Infecting Microorganisms. Int. J. Mol. Sci. 2020, 21, 5105. [Google Scholar] [CrossRef] [PubMed]
- Yingying, L.; Qing, F.; Ying, H.; Chao, L.; Bin, L.; Youming, L. Construction of a Polydopamine@GO/Cellulose Mesoporous Nanofibril Composite Hydrogel with Encapsulation Structure for Controllable Drug Release and Toxicity Shielding. ACS App. Interfaces 2020, 12, 57410–57420. [Google Scholar] [CrossRef]
- Kapusta, O.; Jarosz, A.; Stadnik, K.; Giannakoudakis, D.A.; Barczynski, B.; Barczak, M. Antimicrobial Natural Hydrogels in Biomedicine: Properties, Applications, and Challenges—A Concise Review. Int. J. Mol. Sci. 2023, 24, 2191. [Google Scholar] [CrossRef] [PubMed]
- Ping, H.; Lei, D.; Jiasheng, W.; Xulong, Z.; Jianhui, L.; Zhirong, C.; Yonghao, N. Nanocellulose-based hydrogels as versatile drug delivery vehicles: A review. Int. J. Biol. Macromol. 2022, 222, 830–843. [Google Scholar] [CrossRef]
- Liu, Y.; Sui, Y.; Liu, C.; Liu, C.; Wu, M.; Li, B.; Li, Y. physically crosslinked polydopamine/nanocellulose hydrogel as potential versatile vehicles for drug delivery and wound healing. Carbohydr. Polym. 2018, 188, 27–36. [Google Scholar] [CrossRef] [PubMed]
- Chrintz, H.; Vibits, H.; Cordtz, T.O.; Harreby, J.S.; Waaddegaard, P.; Larsen, S.O. Need for surgical dressing. Br. J. Surg. 1989, 76, 204–205. [Google Scholar] [CrossRef]
- Curvello, R.; Raghuwanshi, V.S.; Garnier, G. Engineering nanocellulose hydrogels for biomedical applications. Adv. Colloid Interface Sci. 2019, 267, 47–61. [Google Scholar] [CrossRef]
- Wang, X.; Wang, Q.; Xu, C. Nanocellulose-based inks for 3d bioprinting: Key aspects in research development and challenging perspectives in applications—A mini review. Bioengineering 2020, 7, 40. [Google Scholar] [CrossRef]
- Feng, Q.L.; Wu, J.; Chen, G.Q.; Cui, F.Z.; Kim, T.N.; Kim, J.O. A mechanistic study of the antibacterial effect of silver ions on Escherichia coli and Staphylococcus aureus. J. Biomed. Mater. Res. 2000, 52, 662–668. [Google Scholar] [CrossRef]
- Pal, S.; Tak, Y.K.; Song, J.M. Does the antibacterial activity of silver nanoparticles depend on the shape of the nanoparticle? Study of the Gram-negative bacteria Escherichia coli. Appl. Environ. Microbiol. 2007, 1712–1720. [Google Scholar] [CrossRef]
- Shuai, L.; Sarmad, A.Q.; Mahpara, Q.; Kanta, B.; Muhammad, B. Engineered nanocellulose-based hydrogels for smart drug delivery applications. Int. J. Biol. Macromol. 2021, 181, 275–290. [Google Scholar] [CrossRef]
- De France, K.J.; Hoare, T.; Cranston, E.D. Review of hydrogels and aerogels containing nanocellulose. Chem. Mater. 2017, 29, 4609–4631. [Google Scholar] [CrossRef]
- Dufresne, A. Nanocellulose: A new ageless bionanomaterial. Mater. Today 2013, 16, 220–227. [Google Scholar] [CrossRef]
- Aramwit, P.; Bang, N. The characteristics of bacterial nanocellulose gel releasing silk sericin for facial treatment. BMC Biotechnol. 2014, 14, 104. [Google Scholar] [CrossRef] [PubMed]
- Shen, X.; Shamshina, J.L.; Berton, P.G.; Gurau, G.; Rogers, R.D. Hydrogels based on cellulose and chitin: Fabrication, properties, and applications. Green Chem. 2016, 18, 53–75. [Google Scholar] [CrossRef]
- Sharma, V.K.; Yngard, R.A.; Lin, Y. Silver nanoparticles: Green synthesis and their antimicrobial activities. ADV Colloid Interface Sci. 2008, 154, 83–96. [Google Scholar] [CrossRef]
- Boselt, I.; Wilke, T.; Waitz, T. School Experiments on the Biotoxicity of Metal and Metal Oxide Nanoparticles. New Perspectives in Science Education. International Conference. Available online: https://conference.pixel-online.net/ (accessed on 14 January 2022).
- Mandal, A.; Chakrabarty, D. Synthesis and Characterization of Nanocellulose Reinforced Full-Interpenetrating Polymer Network Based on Poly (vinyl alcohol) and Polyacrylamide (Both Crosslinked) Composite Films. Polym. Compos. 2017, 38, 1720–1731. [Google Scholar] [CrossRef]
- Bhattacharya, M.; Malinen, M.M.; Lauren, P.; Lou, Y.R.; Kuisma, S.W.; Kanninen, L.; Lille, M.; Corlu, A.; GuGuen-Guillouzo, C.; Ikkala, O.; et al. Nanofibrillar cellulose hydrogel promotes three-dimensional liver cell culture. J. Control. Release 2012, 164, 291–298. [Google Scholar] [CrossRef]
- Sampath, U.G.T.M.; Ching, Y.C.; Chuah, C.H.; Singh, R.; Lin, P.-C. Preparation and characterization of a semi-interpenetrating polymeric network reinforced with chitosan hydrogel nanocellulose. Cellulose 2017, 24, 2215–2228. [Google Scholar] [CrossRef]
- Lin, N.; Dufresne, A. Nanocellulose in biomedicine: Current status and future prospect. J. Eur. Polym. 2014, 59, 302325. [Google Scholar] [CrossRef]
- Oksman, K.; Mathew, A.P.; Bondeson, D.; Kvien, I. Manufacturing process of cellulose whiskers/polylactic acid nanocomposites. Compos. Sci. Technol. 2006, 15, 2776–2784. [Google Scholar] [CrossRef]
- De Gennes, P.G. Scaling Concepts in Polymer Physics; Cornell University Press: Ithaca, NY, USA, 1979. [Google Scholar]
- Klemm, D.; Kramer, F.; Moritz, S.; Lindström, T.; Ankerfors, M.; Gray, D.; Dorris, A. Nanocelluloses: A new family of nature-based materials. Chem. Int. 2011, 50, 5438–546689. [Google Scholar] [CrossRef] [PubMed]
- Ahearne, M. Introduction to cell–hydrogel mechanosensing. Interface Focus 2014, 4, 1–12. [Google Scholar] [CrossRef]
- Durán, N.; Marcato, P.D.; Durán, M.; Yadav, A.; Gade, A.; Rai, M. Mechanistic aspects in the biogenic synthesis of extracellular metal nanoparticles by peptides, bacteria, fungi, and plants. Appl. Microbiol. Biotechnol. 2011, 90, 1609–1624. [Google Scholar] [CrossRef]
- Zhang, X.; Sun, H.; Tan, S.; Gao, J.; Fu, Y.; Zhiguo Liu, Z. Hydrothermal synthesis of Ag nanoparticles on the nanocellulose and their antibacterial study. Inorg. Chem. Commun. 2019, 100, 44–50. [Google Scholar] [CrossRef]
- Tran, Q.H.; Nguyen, V.Q.; Le, A.T. Silver nanoparticles: Synthesis, properties, toxicology, applications, and perspectives. Adv. Nat. Sci. Nanosci. Nanotechnol. 2013, 4, 1–20. [Google Scholar] [CrossRef]
- Lee, S.H.; Jun, B.H. Silver Nanoparticles: Synthesis and Application for Nanomedicine. Int. J. Mol. Sci. 2019, 20, 865. [Google Scholar] [CrossRef]
- Potbhare, A.K.; Chouke, P.B.; Mondal, A.; Thakare, R.U.; Mondal, S.; Chaudhary, R.G.; Rai, A.R. Rhizoctonia solani assisted biosynthesis of silver nanoparticles for antibacterial assay. Mater. Today Proc. 2020, 29, 939–945. [Google Scholar] [CrossRef]
- Potbhare, A.K.; Umekar, M.S.; Chouke, P.B.; Bagade, M.B.; Tarik Aziz, S.K.; Abdala, A.A.; Chaudhary, R.G. Bioinspired graphene-based silver nanoparticles: Fabrication, characterization and antibacterial activity. Mater. Today Proc. 2020, 29, 720–725. [Google Scholar] [CrossRef]
- Mlalila, N.; Swai, H.; Hilonga, A.; Kadam, D. Antimicrobial dependence of silver nanoparticles on surface plasmon resonance bands against Escherichia coli. Nanotechnol. Sci. Appl. 2016, 10, 1–9. [Google Scholar] [CrossRef]
- Sulaiman, G.M.; Ali, E.H.; Jabbar, I.I.; Saleem, A.H. Synthesis, characterization, antibacterial and cytotoxic effects of silver nanoparticles. Dig. J. Nanomater. Biostruct. 2014, 9, 787–796. [Google Scholar]
- Brasil, M.S.L. Antimicrobial Activity of the Combination of Silver Nanoparticles, Chitosan and Antibiotics Evaluated by Minimum Inhibitory Concentration Assays and SERS Spectroscopy. Master’s Thesis, Juiz de Fora Federal University, Juiz de Fora, Brazil, 2017. [Google Scholar]
- Lee, J.H.; Mun, J.; Parque, J.D.; Yu, I.J. A health surveillance case study on workers who manufacture silver nanomaterials. Nanotoxicology 2012, 6, 667–669. [Google Scholar] [CrossRef] [PubMed]
- Munger, M.A.; Radwanski, P.; Hadlock, G.C.; Stoddard, G.; Shaaban, A.; Falconer, J.; Grainger, D.W.; Deering-Rice, C.E. In vivo study of human time exposure of orally dosed commercial silver nanoparticles. Nanomedicine 2014, 10, 1–9. [Google Scholar] [CrossRef] [PubMed]
- Munger, M.A.; Hadlock, G.; Stoddard, G.; Slawson, M.H.; Wilkins, D.G.; Cox, N.; Rollins, D. Assessing orally bioavailable commercial silver nanoparticle product on human cytochrome P450 enzyme activity. Nanotoxicology 2015, 9, 474–481. [Google Scholar] [CrossRef]
- Ibraheem, D.R.; Hussein, N.N.; Sulaiman, G.M.; Mohammed, H.A.; Khan, R.A.; Al Rugaie, O. Ciprofloxacin-Loaded Silver Nanoparticles as Potent Nano-Antibiotics against Resistant Pathogenic Bacteria. Nanomaterials 2022, 12, 2808. [Google Scholar] [CrossRef]
- Bastus, N.G.; Merkoci, F.; Piella, J.; Puntes, V. Synthesis of Highly Monodisperse Citrate-Stabilized Silver Nanoparticles of up to 200 nm: Kinetic Control and Catalytic Properties. Chem. Mater. 2014, 26, 2836–2846. [Google Scholar] [CrossRef]
- Panigrahi, S.; Basu, S.; Praharaj, S.; Pande, S.; Jana, S.; Pal, A.; Ghosh, S.K.; Pal, T. Synthesis and Selective Catalysis by Supported Gold Nanoparticles: Study on Heterogeneous and Homogeneous Catalytic Process. J. Phys. Chem. 2007, 111, 4596–4605. [Google Scholar] [CrossRef]
- Tolaymat, T.M.; El Badawy, A.M.; Genaidy, A.; Scheckel, K.G.; Luxton, T.P.; Suidan, M. An evidence-based environmental perspective of manufactured silver nanoparticle in syntheses and applications: A systematic review and critical appraisal of peer-reviewed scientific papers. Sci. Total Environ. 2010, 408, 999–1006. [Google Scholar] [CrossRef]
- Ilyin, S.; Roumyantseva, T.; Spiridonova, V.; Semakov, A.; Frenkin, E.; Malkin, A.; Kulichikhin, V. Gels of cysteine/Ag-based dilute colloid systems and their rheological properties. J. Soft Matter. 2011, 7, 9090–9103. [Google Scholar] [CrossRef]
- Almeida, E.S. Biosynthesis and Characterization of Silver Nanoparticles by Fusarium oxysporum. Master’s Thesis, Federal University of Santa Catarina, Florianópolis, Brazil, 2016. [Google Scholar]
- Justus, B. Green Synthesis, Characterization and Cytotoxic Evaluation of Functionalized Silver and Gold Nanoparticles for the Potential Treatment of Chronic Myeloid Leukemia. Ph.D. Thesis, State University of Ponta Grossa, Ponta Grossa, Brazil, 2020. [Google Scholar]
- Martins, N.E. Characterization and Evaluation of Biological Activities of Hibiscus sabsariffa L. Extracts and Silver Nanoparticles Obtained by Green Synthesis. Master’s Thesis, Federal University of Piaui, Parnaíba, Brazil, 2018. [Google Scholar]
- Shoeib, T.; Siu, M.K.W.; Hopkinson, A.C. Silver Ion Binding Energies of Amino Acids: Use of Theory to Assess the Validity of Experimental Silver Ion Basicities Obtained from the Kinetic Method. J. Phys. Chem. 2002, 106, 6121–6128. [Google Scholar] [CrossRef]
- Liao, S.; Zhang, Y.; Pan, X.; Zhu, F.; Jiang, C.; Liu, Q.; Cheng, Z.; DAI, G.; Wu, G.; Wang, L.; et al. Antibacterial activity and mechanism of silver nanoparticles against multidrug-resistant Pseudomonas aeruginosa. Int. J. Nanomed. 2019, 14, 1469–1487. [Google Scholar] [CrossRef] [PubMed]
- Salomoni, R.; Léo, P.; Montemor, A.F.; Rinaldi, B.G.; Rodrigues, M.F.A. Antibacterial effect of silver nanoparticles in Pseudomonas aeruginosa. Nanotechnol. Sci. Appl. 2017, 10, 115–121. [Google Scholar] [CrossRef] [PubMed]
- Barani, M.; Zeeshan, M.; Kalantar-Neyestanaki, D.; Farooq, M.A.; Rahdar, A.; Jha, N.K.; Sargazi, S.; Gupta, P.K.; Thakur, V.K. Nanomaterials in the Management of Gram-Negative Bacterial Infections. Nanomaterials 2021, 11, 2535. [Google Scholar] [CrossRef] [PubMed]
- Lambert, P.A. Mechanisms of antibiotic resistance in Pseudomonas aeruginosa. J. R. Soc. Med. 2002, 95, 22–26. [Google Scholar] [PubMed]
- Moyne, O.; Castelli, F.; Bicout, D.J.; Boccard, J.; Camara, B.; Cournoyer, B.; Faudry, E.; Terrier, S.; Hannani, D.; Huot-Marchand, S.; et al. Metabotypes of Pseudomonas aeruginosa Correlate with Antibiotic Resistance, Virulence and Clinical Outcome in Cystic Fibrosis Chronic Infections. Metabolites 2021, 11, 63. [Google Scholar] [CrossRef]
- Dakal, T.C.; Kumar, A.; Majumdar, R.S.; Yadav, V. Mechanistic Basis of Antimicrobial Actions of Silver Nanoparticles. Front. Microbiol. 2016, 7, 1831. [Google Scholar] [CrossRef]
- Mulfinger, L.; Solomon, S.D.; Bahadory, M.; Jeyarajasingam, A.V.; Rutkowsky, S.A.; Boritz, C. Synthesis and Study of Silver Nanoparticles. J. Chem. Educ. 2007, 84, 322. [Google Scholar] [CrossRef]
- Brause, R.; Möltgen, H.; Kleinermanns, K. Characterization of laser-ablated and chemically reduced silver colloids in aqueous solution by UV-vis spectroscopy and STM/SEM microscopy. Appl. Phys. B Lasers Optics. 2002, 75, 711–716. [Google Scholar] [CrossRef]
- Bai, Y.; Yan, L.; Wang, J.; Su, L.; Chen, N.; Tan, Z. Highly reproducible and uniform SERS substrates based on Ag nanoparticles with optimized size and gap. Photonics Nanostruct.—Fundam. Appl. 2017, 23, 58–63. [Google Scholar] [CrossRef]
- Manai, L.; Dridi Rezgui, B.; Benabderrahmane Zaghouani, R.; Barakel, D.; Torchio, P.; Palais, O.; Bessais, B. Tuning of Light Trapping and Surface Plasmon Resonance in Silver Nanoparticles/c-Si Structures for Solar Cells. Plasmonics 2016, 11, 1273–1277. [Google Scholar] [CrossRef]
- Choi, O.; Deng, K.K.; Kim, N.J.; Ross, L.; Surampalli, R.Y.; Hu, Z. The inhibitory effects of silver nanoparticles, silver ions, and silver chloride colloids on microbial growth. Water Res. 2008, 42, 3066–3074. [Google Scholar] [CrossRef] [PubMed]
- Sofi, H.S.; Akram, T.; Shabir, N.; Vasita, R.; Jadhav, A.H.; Sheikh, F.A. Regenerated cellulose nanofibers from cellulose acetate: Incorporating hydroxyapatite (HAp) and silver (Ag) nanoparticles (NPs), as a scaffold for tissue engineering applications. Mater. Sci. Eng. 2021, 118, 111547. [Google Scholar] [CrossRef] [PubMed]
- Medeiros, C.H.S. Study of the Antimicrobial Properties of Nanocellulose Films and Silver Nanoparticles. Ph.D. Thesis, Federal University of São Carlos, São Carlos, Brazil, 2019. [Google Scholar]
- Bundjaja, V.; Santoso, S.P.; Angkawijaya, A.E.; Yuliana, M.; Soetaredjo, F.E.; Ismadji, S.; Ayucitra, A.; Gunarto, C.; Ju, Y.H.; HO, M.H. Fabrication of cellulose carbamate hydrogel-dressing with rarasaponin surfactant for enhancing adsorption of silver nanoparticles and antibacterial. Mater. Sci. Eng. 2021, 118, 111542. [Google Scholar] [CrossRef] [PubMed]
- Oliveira, S.A. Isolation and Purification of Hyaluronic Acid from Chicken Comb and Incorporation into Bacterial Cellulose Membranes. Master’s Thesis, State University of Londrina, Londrina, Brazil, 2017. [Google Scholar]
- Santos, I.A.L. Mechanisms of antimicrobial resistance in Pseudomonas aeruginosa. RBAC 2015, 47, 5–12. [Google Scholar]
- Guimarães, M. Development of Poly(n-butyl-cyanoacrylate) Nanoparticles with Zidovudine Coated with Hyaluronic Acid for Delivery in Gel for Transdermal Use. Ph.D. Thesis, Sao Paulo State University, São Paulo, Brazil, 2015. [Google Scholar]
- Seixas, M.V.S. Obtaining Nanocellulose from Sugarcane Bagasse and Incorporating EVA. Ph.D. Thesis, Sao Paulo State University, São Paulo, Brazil, 2019. [Google Scholar]
- Haxaire, K.; Maréchal, Y.; Milas, M.; Rinaudo, M. Hydration of hyaluronan polysaccharide observed by IR spectrometry. II. Definition and quantitative analysis of the elementary spectra of hydration and water uptake. Biopolymers 2003, 72, 149–161. [Google Scholar] [CrossRef]
- Flanagan, J.N.; Steck, T.R. The Relationship Between Agar Thickness and Antimicrobial Susceptibility Testing. Indian J. Microbiol. 2017, 57, 503–506. [Google Scholar] [CrossRef]
- Lin, Q.; Pilewski, J.M.; Di, Y.P. Acidic Microenvironment Determines Antibiotic Susceptibility and Biofilm Formation of Pseudomonas aeruginosa. Front. Microbiol. 2021, 12, 3459. [Google Scholar] [CrossRef]
- Mellote, P.; Hendrickx, B.; Melin, P.; Mullie, A.; Lapière, C. Efficacy of Silver Sulfadiazine Cream in Treating the Bacteriological Infection of Leg Ulcers. Curr. Ther. Res. 1985, 37, 197–202. [Google Scholar]
- Scandorieiro, S.; Camargo, L.C.; Lancheros, C.A.C.; Yamada-Ogatta, S.F.; Nakamura, C.V.; Oliveira, A.G.; Andrade, C.G.T.J.; Duran, N.; Nakazato, G.; Kobayashi, R.K.T. Synergistic and Additive Effect of Oregano Essential Oil and Biological Silver Nanoparticles against Multidrug-Resistant Bacterial Strains. Front. Microbiol. 2016, 7, 760. [Google Scholar] [CrossRef]
- Izumi, E.; Ueda-Nakamura, T.; Veiga, V.F., Jr.; Pinto, A.C.; Nakamura, C.V. Terpenes from copaifera demonstrated in vitro antiparasitic and synergic activity. J. Med. Chem. 2012, 55, 2994–3001. [Google Scholar] [CrossRef]
- CLSI (The Clinical & Laboratory Standards Institute). Methods for Dilution Antimicrobial Susceptibility Tests of Bacteria That Grow Aerobically, 10th ed.; document M07-A10; CLSI: Wayne, PA, USA, 2015. [Google Scholar]
- NCCLS. Methods for Determining Bactericidal Activity of Antimicrobial Agents; NCCLS: Des Plaines, IL, USA, 1999. [Google Scholar]
- R Core Team. R: A Language and Environment for Statistical Computing. R Foundation for Statistical Computing, Vienna. 2022. Available online: https://www.r-projet.rg (accessed on 2 February 2023).

Disclaimer/Publisher’s Note: The statements, opinions and data contained in all publications are solely those of the individual author(s) and contributor(s) and not of MDPI and/or the editor(s). MDPI and/or the editor(s) disclaim responsibility for any injury to people or property resulting from any ideas, methods, instructions or products referred to in the content. |
© 2023 by the authors. Licensee MDPI, Basel, Switzerland. This article is an open access article distributed under the terms and conditions of the Creative Commons Attribution (CC BY) license (https://creativecommons.org/licenses/by/4.0/).
Share and Cite
Sumini, M.; Souza, C.R.d.; Andrade, G.J.S.; Oliveira, I.R.C.; Scandorieiro, S.; Tischer, C.A.; Kobayashi, R.K.T.; Nakazato, G. Cellulose Hydrogel with Hyaluronic Acid and Silver Nanoparticles: Sustained-Release Formulation with Antibacterial Properties against Pseudomonas aeruginosa. Antibiotics 2023, 12, 873. https://doi.org/10.3390/antibiotics12050873
Sumini M, Souza CRd, Andrade GJS, Oliveira IRC, Scandorieiro S, Tischer CA, Kobayashi RKT, Nakazato G. Cellulose Hydrogel with Hyaluronic Acid and Silver Nanoparticles: Sustained-Release Formulation with Antibacterial Properties against Pseudomonas aeruginosa. Antibiotics. 2023; 12(5):873. https://doi.org/10.3390/antibiotics12050873
Chicago/Turabian StyleSumini, Mirian, Clara Ruiz de Souza, Gabriel Jonathan Sousa Andrade, Igor Roberto Cabral Oliveira, Sara Scandorieiro, Cesar Augusto Tischer, Renata Katsuko Takayama Kobayashi, and Gerson Nakazato. 2023. "Cellulose Hydrogel with Hyaluronic Acid and Silver Nanoparticles: Sustained-Release Formulation with Antibacterial Properties against Pseudomonas aeruginosa" Antibiotics 12, no. 5: 873. https://doi.org/10.3390/antibiotics12050873
APA StyleSumini, M., Souza, C. R. d., Andrade, G. J. S., Oliveira, I. R. C., Scandorieiro, S., Tischer, C. A., Kobayashi, R. K. T., & Nakazato, G. (2023). Cellulose Hydrogel with Hyaluronic Acid and Silver Nanoparticles: Sustained-Release Formulation with Antibacterial Properties against Pseudomonas aeruginosa. Antibiotics, 12(5), 873. https://doi.org/10.3390/antibiotics12050873

